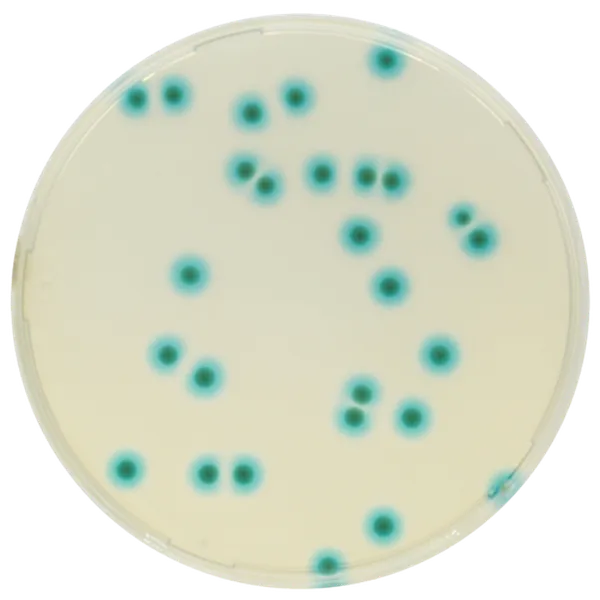
CHROMagar™ B.cepacia

Hình thái khuẩn lạc

Burkholderia
xanh lam +/- quầng xanh dương
Hiệu năng
Hiệu năng
Ứng dụng
Burkholderia cepacia complex (BCC) là một nhóm vi khuẩn Gram âm không lên men lactose, gồm ít nhất 20 loài khác nhau, bao gồm B. cepacia, B. multivorans, B. cenocepacia và B. contaminans. Các loài BCC có thể sống lâu dài và phát triển trong các môi trường khắc nghiệt như dung dịch sát trùng và khử khuẩn, nước cất, bồn tắm xoáy, máy phun sương và ống thông niệu. Hơn nữa, vi khuẩn từ BCC cho thấy sự kháng đa thuốc.
BCC là một trong những tác nhân gây bệnh quan trọng nhất được phân lập từ bệnh nhân xơ nang và nhiễm khuẩn bệnh viện. Tác nhân gây ra các nhiễm trùng đe dọa tính mạng ở bệnh nhân xơ nang, liên quan đến sự suy giảm chức năng phổi. Nó cũng là nguyên nhân gây bệnh tử vong ở bệnh nhân có bệnh u hạt mạn tính. Một số đợt bùng phát BCC đã được mô tả do các loại thuốc, sản phẩm và thiết bị y tế bị nhiễm khuẩn. Do đó, phát hiện và nhận dạng nhanh vi khuẩn từ BCC rất quan trọng đối với bệnh nhân xơ nang, cũng như cho các sản phẩm không vô trùng khác nhau được sử dụng trong bệnh viện và môi trường.
Các loài phát triển chậm nhất của BCC có thể bị bỏ sót trên các môi trường truyền thống như Drigalski hoặc MacConkey Agar do sự phát triển tràn lan của các vi sinh vật khác. CHROMagar™ B.cepacia là môi trường chromogen chọn lọc mạnh sẽ phát hiện hầu hết các vi khuẩn từ BCC trong vòng 24 - 36 giờ.
1. CƯỜNG ĐỘ CAO: Các khuẩn lạc từ Burkholderia cepacia complex (BCC) phát triển với màu xanh-lam đậm, nhìn rõ bằng mắt thường.
4. CÁC CHỦNG QUAN TRỌNG : Một vài chủng không lên men có thể hình thành khuẩn lạc màu xanh-lam. Một số trong các chủng này được báo cáo là có giá trị chẩn đoán.
2. HẠN CHẾ Ô NHIỄM: Nấm mốc bị ức chế nhiều.
5. ĐỘ ĐẶC HIỆU VÀ ĐỘ NHẠY CAO :
Độ nhạy ≈ 100 %*
Độ đặc hiệu = 95 %*
3. TẤT CẢ TRONG MỘT: Tiết kiệm thời gian, bột môi trường được cân sẵn có thể thêm vào nước cất. Không cần bổ sung thêm chất nào khác.
Thành phần

Tài liệu kỹ thuật
Công bố khoa học
2024
Evaluation of CHROMagar™ B.cepacia agar for the detection of Burkholderia cepacia complex species from sputum samples of patients with cystic fibrosis
? Publication2023
Evaluation of a novel chromogenic agar for the detection of Burkholderia cepacia complex from pharmaceutical and cosmetic samples
? Publication2022
Evaluation of a new chromogenic medium for screening of Burkholderia cepacia complex from respiratory specimens
? Publication2022
Evaluation of a new selective chromogenic agar for detection of Burkholderia cepacia complex
? Publication2021
Evaluation du milieu CHROMagar ™ B.cepacia pour la détection de B. cepacia chez les patients atteints de mucoviscidose
? Publication

Xem thêm